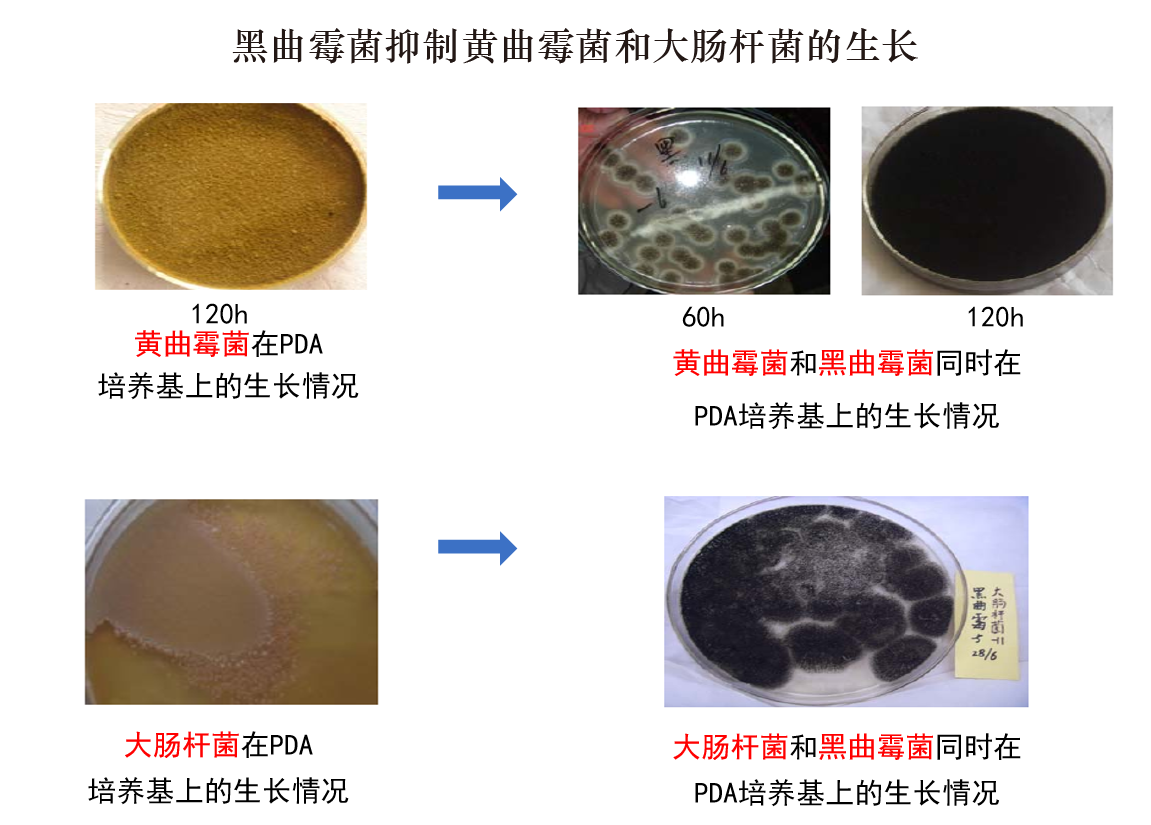

中文简体
在虾的饲养过程中,白便综合症引起高死亡率。怎样解决虾的白便综合症,一时间成为世界性的难题。
目前,很多饲料公司对虾的白便综合症都是采用动保方法加以缓解。
如果哪一家公司的虾料能够减少虾的白便综合症,竞争力必然会大幅提升。甚至不排除,小的饲料公司会逆袭成为大公司。
1928年,英国科学家Fleming发现青霉菌周围的葡萄球菌菌落被溶解。这意味着青霉菌的某种分泌物能抑制葡萄球菌,因此弗莱明将其分泌的抑菌物质称为青霉素(Penicillin,音译盘尼西林)。此后一系列实验证实了青霉素对链球菌、白喉杆菌等多种细菌感染均有效。刘金海(2012)发现在PDA培养基中黑曲霉菌可以有效抑制黄曲霉菌和大肠杆菌的生长。以上都说明了曲霉菌属代谢物中有抑制其他细菌生长的各种作用机制不同的大小生物活性分子。
1939年弗洛里和钱恩给8只小鼠注射了致死剂量的链球菌,然后给其中的4只用青霉素治疗。几个小时后,只有那4只用青霉素治疗过的小鼠还健康活着。这三位科学家的发现,使青霉素进入了人类生活,挽救了成千上万人的生命。一时间青霉素成了家喻户晓的救命药物,当时的价格比黄金还贵。因这项伟大发明,1945年,弗莱明、弗洛里和钱恩共同荣获了诺贝尔生理学或医学奖。青霉素的出现为人们寻找新的药物开辟了新的思路和途径。继青霉素之后,链霉素、金霉素、土霉素等抗生素相继问世。
黑曲霉是美国FDA(食品药品监督管理局)批准允许直接添加的饲料添加剂(蔡辉益,1994),是我国传统发酵工业制酱、酿酒、制醋的主要菌种,也是生产饲用酶制剂(蛋白酶、淀粉酶、果胶酶)的首选菌种。黑曲霉发酵还可生产有机酸(如柠檬酸、葡萄糖酸等)。据统计,25种商业酶制剂,有15种来自黑曲霉。

英赛特试验室抑菌数据表明,黑曲霉是抗菌性能最强的益生素产品,用黑曲霉发酵还可获得具有商业价值的真菌群体物质。黑曲霉菌代谢物中不仅含有抑制其他细菌生长的大小生物活性分子,还具有种类齐全的酶及酶促补充物。钻石菌(水产专用)是采用独特的黑曲霉菌株和定向发酵工艺生产的,含有5个亿的黑曲霉活菌及其定向培养物。高温季节,钻石菌(水产专用)可以给鱼虾等水产动物提供饲料消化所必需的酶和酶促补充物,让水产动物始终保持旺盛的消化能力,减轻水产动物的高温应激死亡。
对于引起水产动物腹泻及虾白便综合症的副溶血弧菌、哈维氏弧菌、嗜水气单胞菌,目前缺乏安全高效、成本合适、效果稳定的治疗手段,但水产专用钻石菌恰好可以抑制这三种关键的有害菌。在高档膨化鱼虾配合饲料中,采用后喷涂设备添加1-3公斤/吨的钻石菌(水产专用)对预防和治疗虾白便综合症以及其他水产动物的肠炎都有效果。
传统的饲料配方思路还是以提供营养为主。然而,在面对虾白便综合症等高死亡率的疾病时,成活率比生长速度更重要。配方师适当降低一下营养指标,省出成本,用到防治疾病、提高成活率上,帮助养殖户提高养殖成功率,饲料就会获得更大的成功。
作者|程相逢
University Putra Malaysia
动物营养硕士
— End —